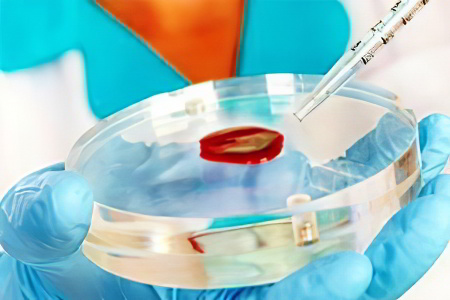
Диагностика остеомиелита Диагностика остеомиелита

Что такое остеомиелит?
Остеомиелит — это инфекционное воспаление всех элементов костной ткани, включая кость, надкостницу и костный мозг. При этом поражается не только кость, но и костный мозг, который увеличивается и отекает. Жесткая оболочка начинает давить на окружающие ткани, что приводит к сжатию кровеносных сосудов и нарушению кровоснабжения в пораженной области. Это может вызвать разрушительные изменения. Если инфекция проникает за пределы кости, например, в мышечные ткани, может возникнуть абсцесс — скопление гноя в полости.
Врачи отмечают, что остеомиелит может быть вызван различными факторами, включая бактериальные инфекции, травмы и хирургические вмешательства. Острая форма заболевания часто развивается внезапно, проявляясь сильной болью в области пораженной кости, отеком и покраснением кожи. Температура тела может повышаться, и пациент может ощущать общее недомогание. Хронический остеомиелит, в свою очередь, может развиваться после неадекватного лечения острого процесса или при наличии сопутствующих заболеваний, таких как диабет. Симптомы хронической формы менее выражены, но могут включать постоянную боль, выделения из свищей и периодические обострения. Врачи подчеркивают важность ранней диагностики и адекватного лечения для предотвращения серьезных осложнений.

Симптомы остеомиелита
Остеомиелит
Остеомиелит — это серьезное заболевание, возникающее из-за внутренней инфекции. Его развитие может происходить всего за два дня, и на этом этапе симптомы могут быть незначительными. Человек может ощущать общее недомогание, мышечные боли и дискомфорт в суставах, не подозревая о начале остеомиелита. Однако вскоре температура тела может подняться до 40 градусов, и появляется сильная боль в области пораженной кости. При движении боль усиливается, что ограничивает подвижность. Заболевание прогрессирует быстро, часто сопровождаясь резким ухудшением состояния, тошнотой и рвотой.
Основная угроза бессимптомного течения остеомиелита заключается в отсутствии лечения, что может привести к переходу болезни из локальной формы в генерализованную, а также из острого состояния в хроническое. Поэтому любые необычные ощущения и повышение температуры без других симптомов требуют внимательной диагностики.
При токсической форме остеомиелита наблюдаются падение артериального давления, боли в сердце, возможны судороги и потеря сознания. Лицо становится бледным, глаза западают, кожа может желтеть, а губы приобретать синеватый оттенок. В случае травматической формы остеомиелита крайне важно немедленно обратиться к врачу, так как это может привести к летальному исходу.
Травматический остеомиелит проявляется острыми симптомами, включая высокую температуру и сильную боль в области травмы. Позже эти симптомы могут смениться хроническими проявлениями. Человек может чувствовать себя относительно нормально, однако гнойные выделения могут выходить через свищевые ходы, образующиеся в области раны, что является одной из причин травматического остеомиелита. Тяжелая форма заболевания может привести к заражению крови.
Клинические проявления остеомиелита делятся на два типа:
- локальный;
- генерализованный.
Локальная форма характеризуется следующими симптомами:
- Повышение температуры тела до 38,5 °C.
- Образование отеков и выпуклостей на пораженном участке.
- Ломота и распирающая боль.
- Нагревание и покраснение кожи в проблемной зоне.
- Появление абсцессов.
- Выделение гноя через кожу.
- Болезненность и ограничение движений.
Генерализованная форма проявляется другими признаками:
- Температура может повышаться до 39–40 градусов;
- Боль становится постоянной и усиливается;
- Нарастает общая интоксикация (плохое самочувствие);
- Появляются озноб, липкий пот и хриплая одышка;
- Неврологические симптомы (судороги, бред, потеря сознания);
- Нарушения работы почек (болезненное и частое мочеиспускание);
- Бледность кожных покровов.
| Причина | Симптомы острого остеомиелита | Симптомы хронического остеомиелита |
|---|---|---|
| Бактериальная инфекция (чаще Staphylococcus aureus) | Высокая температура, озноб, сильная боль в пораженной кости, покраснение и отечность кожи над очагом инфекции, ограничение подвижности сустава, лейкоцитоз | Тупая, ноющая боль в пораженной кости, периодические обострения с повышением температуры и усилением боли, образование свищей с выделением гноя, укорочение конечности, деформация кости, ограничение функции конечности |
| Травма (открытый перелом, операция) | Быстрое развитие симптомов, выраженная интоксикация | Медленное развитие симптомов, длительное течение заболевания, периодические обострения |
| Гематогенное распространение инфекции | ||
| Иммунодефицитные состояния | Появление симптомов может быть отсрочено, течение заболевания более тяжелое | |
| Неадекватное лечение острого остеомиелита |
Причины остеомиелита
Основными возбудителями острого остеомиелита являются стафилококки, но также могут участвовать другие бактерии, риккетсии и некоторые виды грибов, проникающие в костную ткань и вызывающие заболевание.
Чаще всего причиной недуга становится золотистый стафилококк. Однако его могут вызывать и определенные штаммы кишечных палочек, гемолитический стрептококк и синегнойная палочка. Остеомиелит может быть вызван как одним патогенным микроорганизмом, так и их комбинацией.
Для начала воспалительного процесса необходимы определенные условия, которые можно разделить на предрасполагающие факторы и триггеры.
К предрасполагающим факторам остеомиелита относятся:
- скрытые инфекции;
- аллергические расстройства;
- снижение иммунной защиты;
- физическое истощение;
- длительное голодание и нехватка питательных веществ.
Триггеры, способствующие развитию болезни:
- различные травмы;
- ожоги и обморожения;
- острые респираторные вирусные инфекции;
- чрезмерные физические нагрузки;
- нарушения психоэмоционального состояния (стресс, длительное нервное напряжение).
Существует три основных пути инфицирования:
- через кровеносную систему;
- прямое внедрение патогенных микроорганизмов (например, при травмах или ожогах);
- распространение инфекции с соседних участков организма.
К факторам риска можно отнести:
- туберкулез;
- язвенные заболевания;
- травмы;
- повреждения, вызванные термическими ожогами;
- нарушения кровообращения;
- инфекционные болезни носовых пазух, полости рта и стоматологические проблемы;
- сахарный диабет;
- онкологические заболевания и их лечение (например, химиотерапия);
- хирургические вмешательства.
У детей грудного и младшего возраста часто наблюдается гематогенный остеомиелит, когда микробы из очага инфекции, например, из больного зуба, проникают в костномозговой канал длинных трубчатых костей рук или ног. Редко остеомиелит возникает из-за инфекции мягких тканей, которая переходит на соседние кости. Открытые переломы также могут стать причиной остеомиелита, когда инфекция проникает в кость через рану.
Причины возникновения остеомиелита до сих пор остаются неясными. Существует три основные теории, объясняющие механизмы развития заболевания (сосудистая, нервно-рефлекторная и аллергическая), но ни одна из них не получила достаточного подтверждения, чтобы считаться окончательной.
Острый и хронический остеомиелит — это серьезные заболевания, которые вызывают множество вопросов и обсуждений среди людей. Многие отмечают, что острый остеомиелит часто начинается с резкой боли в области пораженной кости, отека и покраснения. Симптомы могут развиваться быстро, и пациенты часто испытывают лихорадку и общее недомогание. В то же время хронический остеомиелит может проявляться менее ярко: боль может быть периодической, а симптомы — менее выраженными. Люди делятся своими историями о том, как долго они страдали от недуга, прежде чем обратились за медицинской помощью. Часто упоминается, что запущенные случаи могут привести к серьезным осложнениям, таким как некроз тканей. Важно, чтобы пациенты знали о необходимости своевременной диагностики и лечения, так как это может существенно повлиять на качество жизни и восстановление.

Острый остеомиелит
В зависимости от способа проникновения инфекционного агента в ткани острый остеомиелит делится на эндогенную и экзогенную формы. Эндогенный (гематогенный) тип возникает, когда инфекция проникает в организм через кровеносные сосуды из других источников заболевания под воздействием определённых факторов.
К экзогенной форме относятся:
- контактный;
- посттравматический;
- огнестрельный;
- послеоперационный.
Острый гематогенный остеомиелит
Способ заражения заключается в проникновении патогенных бактерий в кровеносные сосуды костной ткани, что приводит к образованию первичного очага инфекции. Наибольшему риску подвержены дети в возрасте от 3 до 15 лет, но заболевание может встречаться и у новорождённых, а также у людей среднего и пожилого возраста. Гематогенный остеомиелит чаще наблюдается у мужчин и имеет пик заболеваемости с весны до осени. Эта форма заболевания особенно «предпочитает» длинные кости, такие как бедренная, большеберцовая и плечевая.
По характеру течения болезни выделяют четыре формы гематогенного остеомиелита:
- Обрывная форма – самая лёгкая и благоприятная. Организм активирует защитные механизмы и восстанавливающие системы, что позволяет ликвидировать очаг инфекции за 2–3 месяца.
- Затяжная форма – длится значительно дольше, до 6–8 месяцев. Несмотря на продолжительность выздоровления, болезнь со временем отступает.
- Молниеносная форма – самая тяжёлая и непредсказуемая. Чаще всего вызывается стафилококковой инфекцией и характеризуется резким выбросом в кровь продуктов распада бактерий. Это приводит к резкому снижению артериального давления до критических значений, и без немедленной медицинской помощи может наступить летальный исход.
- Хроническая форма – продолжается более 8 месяцев и сопровождается рецидивами (обострениями) и ремиссиями (ослаблением воспалительного процесса). Часто наблюдается образование секвестров – омертвевших участков ткани, что способствует затяжному воспалению. Формируются свищи, которые открываются во время рецидивов и закрываются в период ремиссий. Хроническая стадия может привести к атрофии мышц и амилоидозу, нарушающему белковый обмен в организме.
Также выделяется первично-хроническая форма, которая становится всё более распространённой в последние годы.
Эксперты связывают рост числа случаев этой формы остеомиелита с рядом факторов:
- неправильное питание;
- недостаток необходимых микроэлементов в рационе;
- ухудшение экологической ситуации за последние десятилетия;
- нерациональное и чрезмерное применение антибиотиков;
- ограничение физической активности.
Первично-хроническая форма делится на несколько типов:
- абсцесс Броди;
- альбуминозный;
- антибиотический;
- склерозирующий.
Первично-хронический остеомиелит отличается медленным течением, что затрудняет диагностику.

Острый одонтогенный остеомиелит
Одонтогенный остеомиелит
Одонтогенный тип представляет собой инфекционное поражение костей челюсти, сопровождающееся гнойно-некротическим процессом. Большинство пациентов с этим видом остеомиелита — мужчины старше 35 лет. Чаще всего страдает нижняя челюсть (до 85% случаев), тогда как поражение верхней челюсти встречается лишь в 15% случаев и протекает значительно легче.
К основным причинам возникновения данного заболевания относятся:
- общее снижение иммунной защиты организма;
- ошибки, допущенные во время хирургических стоматологических процедур;
- стоматологические заболевания (кисты зубов, периодонтит);
- болезни носоглотки (фронтит, этмоидит, гайморит);
- нарушения обмена веществ;
- резкий рост числа условно-патогенных микроорганизмов;
- прямое инфицирование в результате травм и термических повреждений.
Прогрессирование болезни сопровождается образованием мелких кровоизлияний, вызванных тромбозом сосудов костной ткани. Это приводит к появлению гнойных очагов различного размера и вызывает отмирание отдельных участков тканей. Также могут возникать изолированные очаги некроза, что указывает на нозологические формы одонтогенного остеомиелита.
Симптоматика заболевания включает острую боль, которая может иррадиировать в область висков, носовых пазух и лба. Боль ощущается на стороне челюсти, где расположен очаг инфекции. Также наблюдаются повышение температуры тела, повышенная потливость, озноб и общее ухудшение самочувствия.
Хронический остеомиелит
При запущенном остром остеомиелите, если не предпринять своевременные меры, может наступить подострый период, который затем переходит в хроническую стадию. Эта форма заболевания длится от 2–3 месяцев до 8–12 месяцев, а в некоторых случаях — и несколько лет. Хронический остеомиелит характеризуется образованием секвестров и свищей, а также чередованием периодов обострений и ремиссий.
Хронический одонтогенный остеомиелит
Приблизительно через неделю после резкого начала одонтогенного остеомиелита наступает подострая стадия, которая может перейти в хроническую форму в течение 3–5 дней. Основные факторы, способствующие этому переходу:
- общее ослабление иммунной системы;
- переохлаждение организма;
- физическое и эмоциональное переутомление;
- острые респираторные инфекции;
- неправильные действия при лечении острого одонтогенного процесса.
Клинические проявления:
- незначительное повышение температуры (около 37,5 градусов);
- легкое недомогание и общая слабость;
- образование свищей и секвестров;
- выделение гноя и мелких участков омертвевших тканей через свищевые отверстия;
- проблемы со сном.
На рентгеновских снимках и результатах компьютерной томографии четко видны чередования здоровых участков тканей с зонами повреждений различной формы и размеров.
Гематогенный хронический остеомиелит
При переходе от острого воспаления к подострой и затем к хронической стадии температура тела снижается до субфебрильных значений, а иногда и полностью нормализуется. Ярко выраженные болевые ощущения исчезают. В пораженной области наблюдаются уплотнение, ограничение подвижности и отечность. В месте хирургического разреза может образоваться свищ, через который выделяется гной. В некоторых случаях происходит самопроизвольный разрыв тканей, что приводит к образованию нескольких свищей, которые могут сохраняться на протяжении месяцев и даже лет. Также могут формироваться как одиночные крупные секвестры, так и небольшие группы омертвевших тканей.
Если гной не может выйти наружу и скапливается под мягкими тканями, возникает отек, кожа становится горячей и краснеет, появляется боль и повышенная температура. Как только свищ открывается и гной выходит, симптомы исчезают.
Для диагностики используются рентгенографические исследования, которые могут выявить изменения уже на 12–14 день после завершения острого периода. На этом этапе особенно полезен метод фистулографии, представляющий собой компьютерную томографию с контрастным веществом. Четкое изображение позволяет точно определить размеры секвестров, их расположение и степень выраженности заболевания.
Насколько серьёзен остеомиелит?
После установления диагноза и квалифицированной консультации пациенты часто ошибочно считают, что остеомиелит — это простое воспаление, затрагивающее лишь небольшой участок кости и не влияющее на другие процессы в организме. В результате они не осознают всей серьезности своего состояния и не придают должного значения лечению. Это может привести к серьезным осложнениям, а в некоторых случаях — к летальному исходу. Поэтому важно донести до пациента информацию о том, насколько опасно это заболевание и какие последствия оно может вызвать.
Следует обратить внимание на то, что остеомиелит значительно ухудшает функционирование печени и почек, приводит к общему истощению организма и снижению иммунной защиты. Иногда пациент умирает не от самого остеомиелита, а от заболеваний, вызванных им, особенно если поражаются органы, которые уже имели проблемы со здоровьем.
Диагностика остеомиелита
При осмотре проводится аккуратная пальпация болезненного участка. Важно обратить внимание на состояние кожи: наличие жара, покраснения, отека и волнообразные движения тканей. Также оценивается внешний вид пораженной области: натянутые кожные покровы, «глянцевый» блеск и отечность. Осторожная перкуссия (постукивание) помогает выявить очаг инфекции, что проявляется в усилении боли в определенной зоне припухлости.
Кроме клинических проявлений и ручного осмотра, применяются лабораторные методы исследования:
- Общий анализ крови с детализированной лейкоцитарной формулой показывает сдвиг влево, указывая на бактериальную природу воспаления. Нейтрофилы, отвечающие за подавление инфекции, представлены в четырех формах: сегментоядерные, палочкоядерные, юные нейтрофилы и миелоциты. При сдвиге формулы влево увеличивается количество сегментоядерных нейтрофилов и появляются палочкоядерные формы. Чем острее и тяжелее инфекция, тем больше юных форм нейтрофилов в анализе. Также показатели, такие как СОЭ (скорость оседания эритроцитов), уровень гемоглобина и тромбоцитов, помогают понять характер заболевания.
- Общий анализ мочи может выявить воспаление и почечную недостаточность (в случае генерализованных форм заболевания) через появление белка и увеличение некоторых показателей.
- Биохимический анализ крови позволяет выявить воспалительный процесс и указывает на почечную и печеночную недостаточность. При этом изменяются параметры билирубина и белка, наблюдается снижение уровня глюкозы и увеличение количества некоторых элементов.
В дополнение к лабораторным методам используются инструментальные способы обследования:
- Ультразвуковое исследование применяется для оценки размеров и формы мышечного поражения.
- Инфракрасное сканирование может выявить острые скрытые формы остеомиелита, определяя участки с повышенной температурой.
- Рентгенография — наиболее распространенный метод диагностики остеомиелита. С помощью рентгеновских снимков можно определить локализацию некротических процессов, объем и степень выраженности инфекционного очага. Рентген позволяет выявить заболевание на ранних стадиях, а по мере прогрессирования воспаления изменяется характер изображений, что помогает точно определить время течения болезни.
- Компьютерная томография — наиболее информативный метод диагностики остеомиелита в любых его формах. Объемные изображения предоставляют данные о локализации и интенсивности инфекции, а также позволяют создать реконструкцию окружающих мышечных тканей и спрогнозировать течение заболевания.
Для постановки точного диагноза, который играет ключевую роль в лечении остеомиелита, необходимо сочетание лабораторных и инструментальных методов исследования.
Как происходит лечение?
Лечение остеомиелита должно быть комплексным и своевременным. Важно постоянно контролировать состояние пациента, так как заболевание может сопровождаться неожиданными осложнениями и различными проявлениями. Для эффективной борьбы с остеомиелитом рекомендуется сочетание медикаментозной терапии, хирургических вмешательств и физиотерапевтических процедур.
Принципы медикаментозного (консервативного) лечения
Основной аспект: лечение остеомиелита исключительно медикаментозными средствами без хирургического вмешательства не дает ожидаемых результатов. Недостаточная доза антибиотиков может привести к мутациям патогенных микроорганизмов, что делает их устойчивыми к терапии.
При внутрикостном введении смеси физиологического раствора и антибиотиков происходит промывание очага инфекции. Это создает защитный барьер, который препятствует распространению возбудителей за пределы пораженной области. Промывание также снижает давление в костной ткани, удаляет гной и уменьшает болевые ощущения.
Антибактериальное средство выбирается в зависимости от чувствительности конкретного вида бактерий-возбудителей. Лекарство вводится в костную полость и применяется в течение 1-2 месяцев. В некоторых случаях курс антибиотиков может быть продлён до 3-4 месяцев. Общая продолжительность антибиотикотерапии зависит от тяжести и характера заболевания.
Ключевые моменты:
- В период лечения рекомендуется иммобилизация (ограничение подвижности) пораженной области с использованием специальных устройств. Важно также снизить физическую активность.
- При длительном курсе антибиотикотерапии целесообразно применять средства, повышающие общую сопротивляемость организма. Для этого проводятся инфузии (внутривенные вливания) специальных растворов и используются препараты крови.
- В случаях тяжелого поражения может быть назначено ультрафиолетовое облучение крови.
- При развитии сепсиса необходимо провести процедуры для очистки крови и лимфатической системы от токсинов.
- В процессе лечения требуется тщательный контроль за электролитным балансом организма.
Комплекс лечебной физкультуры может быть применен только после завершения острого периода болезни и устранения болевого синдрома. Лечебная физкультура способствует восстановлению функций поврежденных участков, активирует работу мышечной ткани и обеспечивает поступление питательных веществ и витаминов в зону поражения.
Хирургическое лечение
Оперативное вмешательство становится невозможным при наличии сопутствующих заболеваний в декомпенсированной стадии, так как это может привести к более серьезным осложнениям, чем остеомиелит.
Показания для хирургического вмешательства при остеомиелите:
- атипичная форма заболевания;
- наличие гнойных процессов;
- разлитое гнойное воспаление (флегмона) надкостницы;
- образовавшиеся секвестры;
- свищи;
- многократные рецидивы болезни.
Главное правило — удалить гнойный очаг, независимо от его размеров. Подготовка к операции включает дезинтоксикацию, введение препаратов для поддержки иммунной системы, проверку обмена веществ и, при необходимости, применение корректирующих средств.
Хирургическое вмешательство проводится под общим обезболиванием. Каждая операция имеет свои этапы, которые зависят от конечной цели и ожидаемого результата.
В общем, процесс хирургического вмешательства выглядит следующим образом:
- Обрабатывается операционное поле антисептическими средствами, проверяются инструменты.
- Оценивается действие анестезии, и при удовлетворительном состоянии выполняется первый разрез.
- С помощью последующих разрезов хирург добирается до очага инфекции, который чаще всего располагается внутри кости.
- Открывается костный участок над очагом, соответствующий размеру воспаления. Если имеются признаки разлитого гнойного воспаления, сначала устраняются гнойные массы.
- Сверлят небольшие отверстия, образующие вытянутый прямоугольник. Затем с помощью электрического хирургического лобзика отверстия соединяются разрезом, в результате чего получается костная пластина, которая удаляется. Открывается дно костномозгового канала, где сосредоточен очаг остеомиелита.
- Канал промывается антисептическими растворами, в него устанавливается дренажная трубка с боковыми отверстиями и свободным краем, который фиксируется за пределами разреза.
- Завершающий этап — послойное ушивание раны.
После операции с помощью установленного дренажа осуществляется промывание полости антибактериальными растворами. Оценивается содержимое: если выделения указывают на чистоту внутрикостной полости, выполняется повторное открытие раны и замена дренажа на участок поперечнополосатой ткани с прикрепленным сосудом для питания (хирургическая пластика). Это необходимо для предотвращения рецидивирующего остеомиелита. Дренаж устанавливается в мягких тканях и удаляется по мере заживления.
Лечение огнестрельного и хронического посттравматического остеомиелита
При лечении остеомиелита, вызванного огнестрельными ранениями, основное внимание уделяется радикальному хирургическому вмешательству. Во время операции удаляются инородные тела, фрагменты костей и мертвые ткани. Затем область раны обрабатывается антибактериальными средствами, а при необходимости устанавливается дренаж. После операции пациенту назначается курс противомикробной терапии, витаминные инъекции и процедуры по выведению токсинов из организма.
Хроническая посттравматическая форма остеомиелита часто сопровождается дефектами, такими как переломы, укорочение кости и ложные суставы. Для устранения свищей и соединения костных фрагментов обычно применяется метод остеосинтеза. Этот метод обеспечивает надежную фиксацию отломков в правильном анатомическом положении, что способствует их сращению. При возникновении флегмоны необходимо вскрыть очаг, удалить гной и некротические ткани, а также провести дренирование образовавшейся полости.
Лечебная физкультура при остеомиелите
После хирургической операции занятия лечебной физкультурой для повреждённой области можно начинать не ранее чем через 20 дней. Однако другие участки тела, не подвергавшиеся операции, нуждаются в активности. Рекомендуется выполнять «зарядку» дважды в день по 10–15 минут, чтобы предотвратить образование пролежней и улучшить кровообращение в тканях.
Со временем продолжительность упражнений постепенно увеличивается, увеличивая нагрузку и плавно переходя к поражённой области. На завершающем этапе лечебной физкультуры основное внимание уделяется восстановлению правильных движений в повреждённой зоне.
На этапе восстановления также эффективно применять физиотерапевтические методы, такие как электрофорез, ультрафиолетовое облучение и терапия с использованием ультравысоких частот.
Вопросы питания
Правильно составленный рацион при остеомиелите играет ключевую роль в комплексном лечении заболевания. Рекомендуется разбивать питание на 5–6 небольших приёмов пищи в день для лучшего усвоения. В меню должны быть молочные продукты, мясные изделия, яйца, а также свежие овощи и фрукты. Объём жидкости должен составлять не менее 2,5 литров в сутки. Важно включать продукты, богатые железом, кальцием и белком. Если у пациента есть сопутствующие заболевания, требующие особого подхода к питанию, все вопросы следует обсуждать с лечащими врачами.
Прогноз заболевания
При диагностировании острого или хронического остеомиелита важно составить прогноз, который зависит от формы заболевания и общего состояния пациента на момент госпитализации. Ключевыми факторами являются возраст, уровень иммунной защиты, стадия болезни и скорость её обнаружения. Чем раньше начнется комплексное лечение, тем выше вероятность полного выздоровления. Наиболее неблагоприятный прогноз наблюдается у пациентов с запущенной формой хронического остеомиелита, особенно при истончении костной ткани.
Вопрос-ответ
Каковы симптомы хронического остеомиелита?
Как проявляется хронический остеомиелит? Переход остеомиелита в хроническую стадию характеризуется другими симптомами, а также улучшением состояния. Появляются свищи, из которых выходит гной. Образуются секвестры, участки омертвевшей ткани. Иногда могут образовываться не секвестры, а полости, заполненные гноем.
Каковы причины остеомиелита?
Причины остеомиелита. Причиной заболевания является инфицирование костной ткани. Болезнетворные микроорганизмы попадают в кости через кровь из очагов воспаления внутри организма, а также извне при загрязнении открытых ран, обсеменении патогенами эндопротезов и агрессивном течении инфекционных процессов в мягких тканях.
Чем отличается острый остеомиелит от хронического?
Без лечения острый гнойный процесс превращается в хронический остеомиелит. В результате распространения (если не произошла хронизация острого процесса) гнойного процесса появляется гнойный артрит. Также острый остеомиелит вызывает острое разлитое гнойное воспаление в жировой клетчатке (флегмона).
Какой признак острого остеомиелита возникает в первую очередь?
Симптомы острого остеомиелита. Один из первых признаков остеомиелита – сильная боль в пораженной области. Боль ощущается глубокой, распирающей и быстро усиливается при движении или надавливании. Участок кожи над воспаленной костью становится горячим, красным и отечным.
Советы
СОВЕТ №1
Обратите внимание на симптомы. Если вы заметили такие признаки, как сильная боль в области кости, отек, покраснение или повышение температуры в месте воспаления, не откладывайте визит к врачу. Раннее обращение за медицинской помощью может предотвратить серьезные осложнения.
СОВЕТ №2
Следите за состоянием раны. Если у вас есть открытые раны или травмы, особенно на конечностях, регулярно проверяйте их на наличие признаков инфекции, таких как гной, неприятный запах или увеличение отека. При появлении таких симптомов немедленно обратитесь к врачу.
СОВЕТ №3
Укрепляйте иммунную систему. Правильное питание, регулярные физические нагрузки и достаточный сон помогут вашему организму лучше справляться с инфекциями. Включите в рацион продукты, богатые витаминами и минералами, особенно витамином C и цинком.
СОВЕТ №4
Следуйте рекомендациям врача. Если вам поставили диагноз остеомиелит, строго придерживайтесь назначенного лечения, включая курс антибиотиков и, при необходимости, физиотерапию. Это поможет избежать перехода заболевания в хроническую форму.